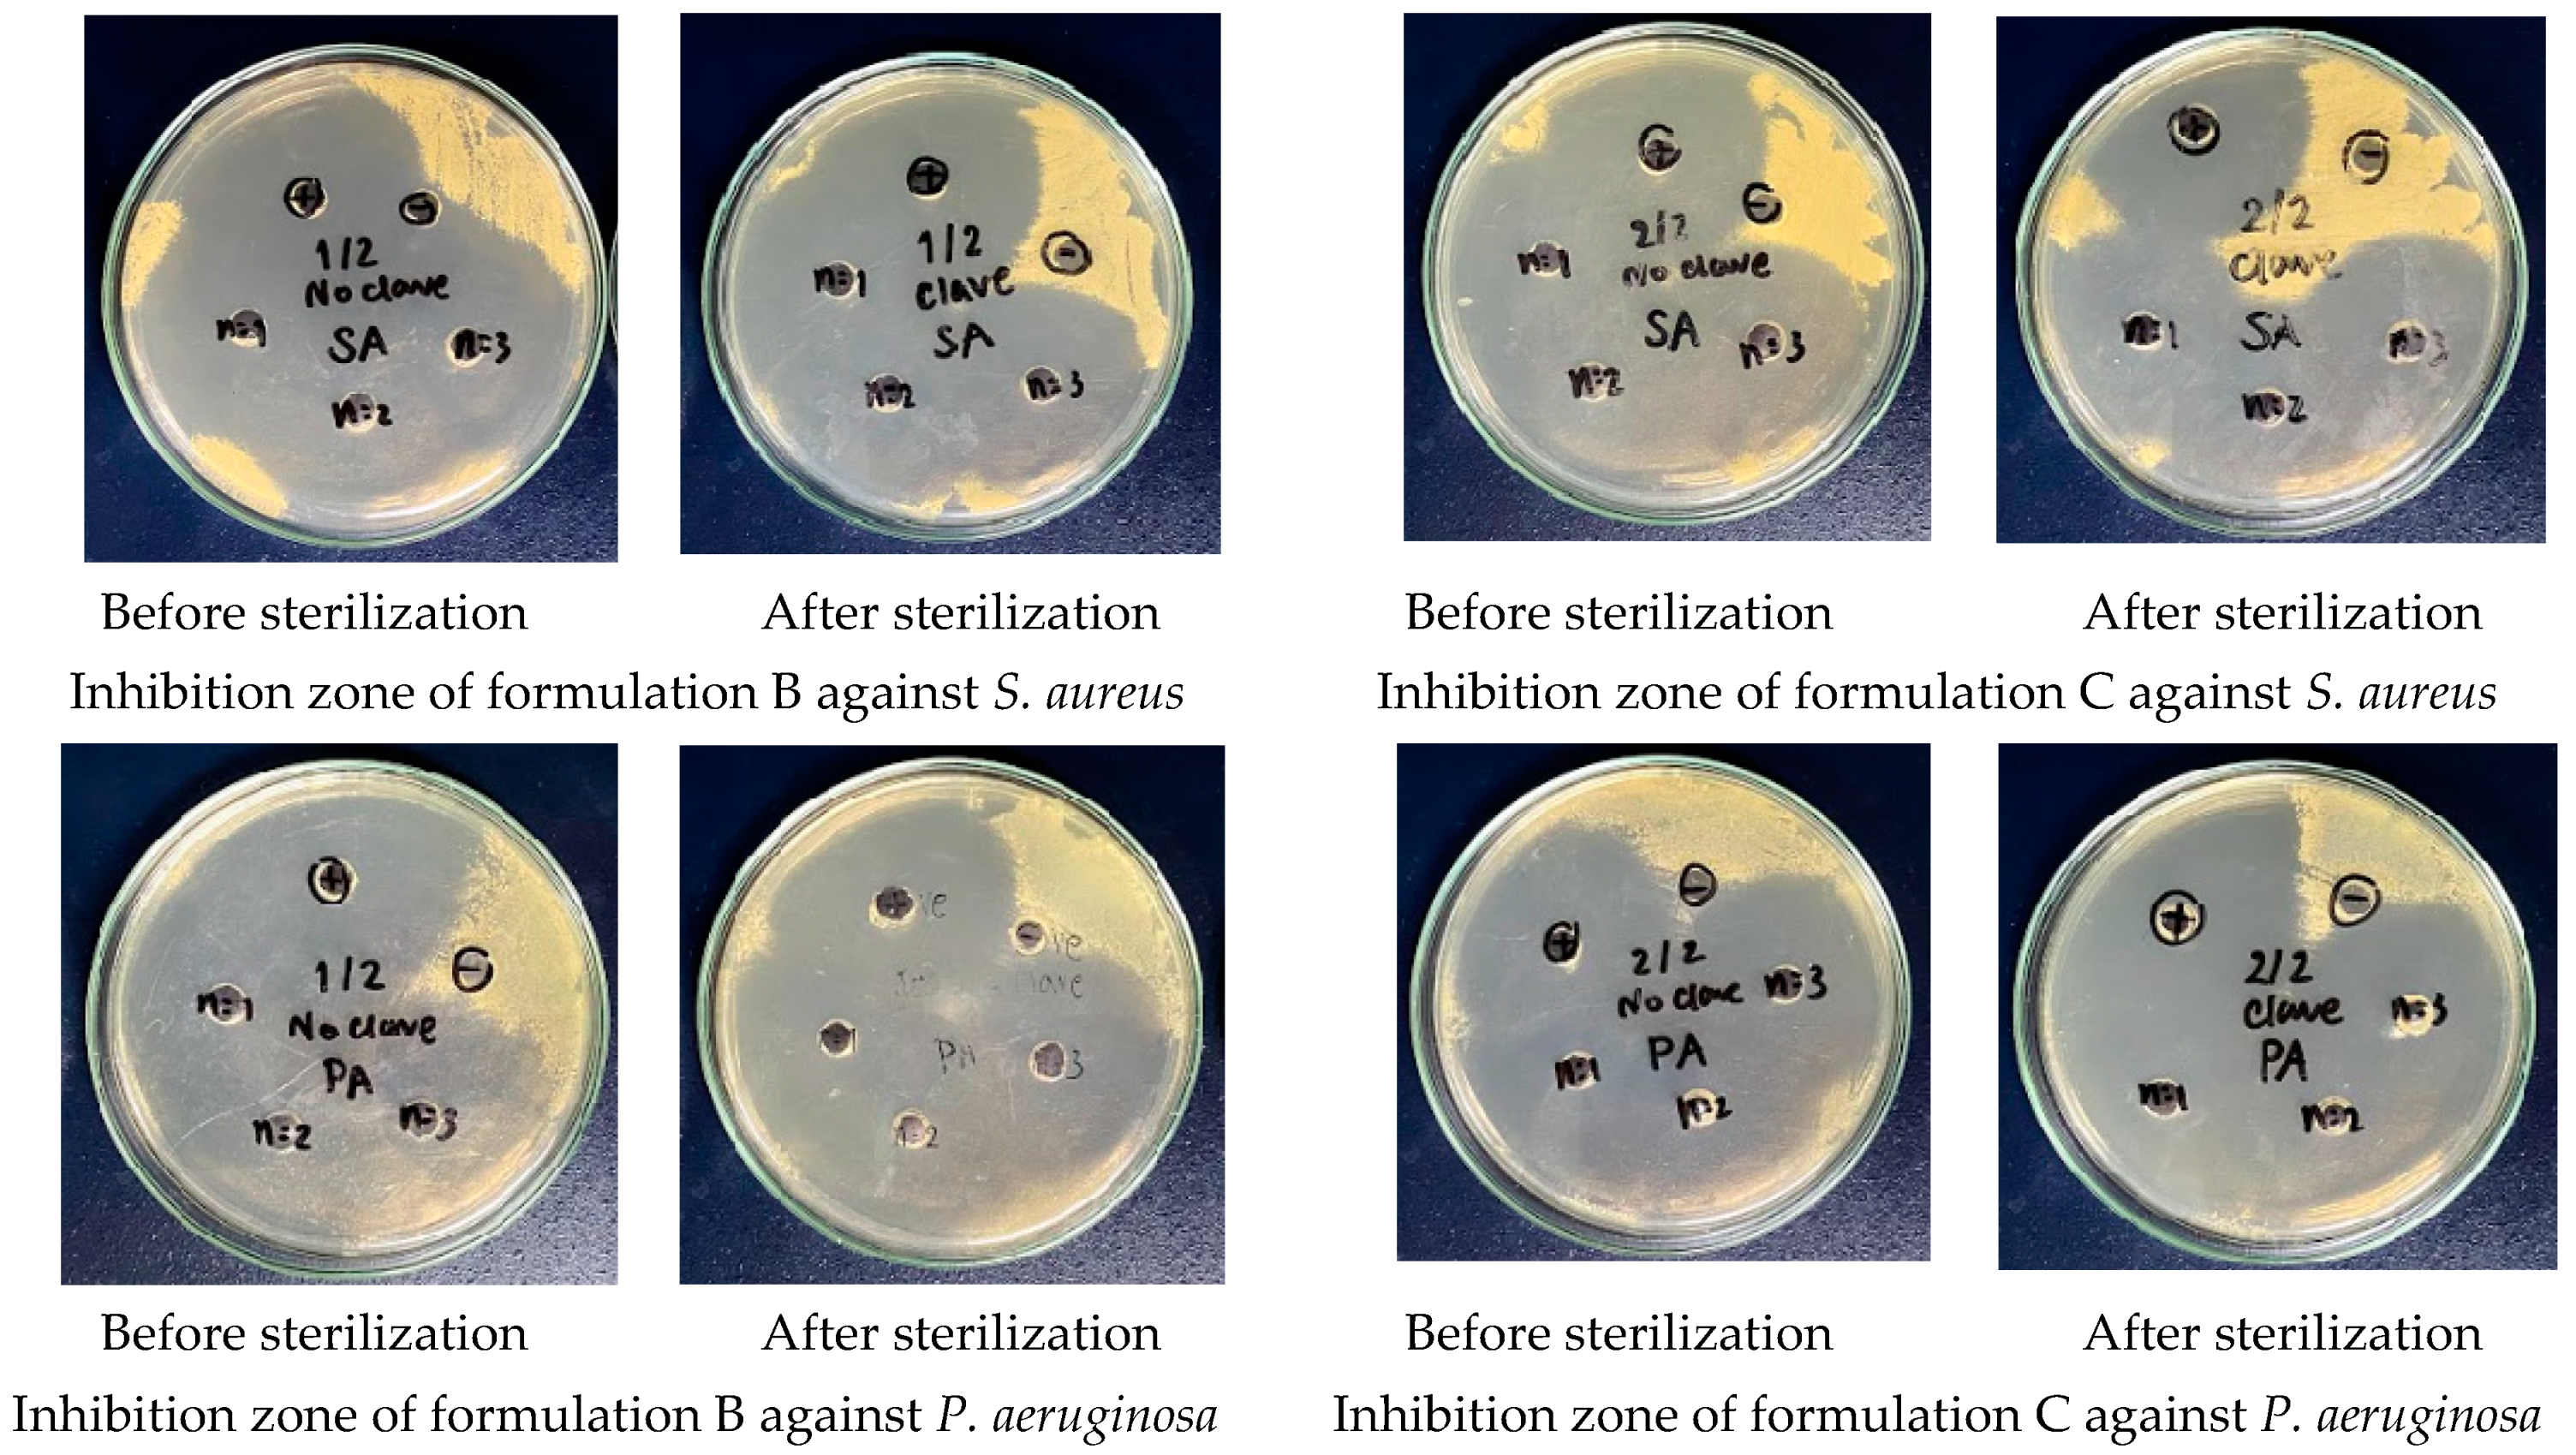
Ijms 26 04458 g008

Impact of Vehicle Composition on Solubility, Autoclave Sterilization Stability, and Antibacterial Activity of Ciprofloxacin Hydrochloride Ear Drops
Abstract
1. Introduction
2. Results
2.1. Effect of pH on Solubility of Ciprofloxacin
2.2. Vehicle Selection for Improveing Solubility of Ciprofloxacin at Physiological pH
2.3. Validation of Analytical Method for Determination of Ciprofloxacin Hydrochloride Eardrops
2.4. Stability of 0.33% Ciprofloxacin HCl Ear Drops Following Autoclave Sterilization
2.4.1. Chemical Stability of 0.33% Ciprofloxacin HCl Ear Drops Under Sterilization Conditions
2.4.2. Antimicrobial Efficacy of 0.33% Ciprofloxacin HCl Ear Drops
2.5. Storage Stability of 0.33% Ciprofloxacin HCl Ear Drops
3. Discussion
4. Materials and Methods
4.1. Materials
4.2. Calculation of Hansen Solubility Parameters
4.3. Preparation of 0.33% Ciprofloxacin HCl Eardrops
4.4. Determination of the Effect of pH on Ciprofloxacin Solubility
4.5. HPLC Analysis of Ciprofloxacin Ear Drops
4.6. Method Validation
4.6.1. Specificity
4.6.2. Linearity
4.6.3. Limit of Detection (LOD) and Limit of Quantification (LOQ)
4.6.4. Accuracy
4.6.5. Precision
4.7. Evaluation of Antimicrobial Activity of 0.33% Ciprofloxacin HCl Ear Drops
4.7.1. Preparation of Microbial Cultures
4.7.2. Antimicrobial Well Diffusion Assay
4.8. Statistical Analysis
5. Conclusions
Author Contributions
Funding
Institutional Review Board Statement
Informed Consent Statement
Data Availability Statement
Acknowledgments
Conflicts of Interest
Abbreviations
| AOAC | Association of Official Analytical Collaboration |
| °C | Celsius degree |
| cm | Centimeter |
| CSOM | chronic suppurative otitis media |
| HCl | Hydrochloride |
| HPLC | High Performance Liquid Chromatography |
| HSP | Hansen Solubility Parameters |
| ICH | The International Council for Harmonisation of Technical Requirements for Pharmaceuticals for Human Use |
| Kg | Kilogram |
| L | Litter |
| LOD | Limit of Detection |
| LOQ | Limit of Quantitation |
| mL | Milliliter |
| Mol | Mole |
| MW | Molecular weight |
| NaOH | Sodium hydroxide |
| NF | National Formulary |
| pH | Potential of Hydrogen |
| pHp | precipitation pH |
| pKa | Acid dissociation constant |
| SD | Standard deviation |
| TSB | Tryptic soy broth |
| USP | United State Pharmacopeia |
| δd | Dispersion force |
| δh | Hydrogen bonding energy |
| δp | Dipolar intermolecular force |
| µg | Micro gram |
| µM | Micro molar |
| %RSD | Percentage relative standard deviation |
References
- Shangali, A.; Kamori, D.; Massawe, W.; Masoud, S.; Kibwana, U.; Mwingwa, A.G.; Manisha, A.; Mwandigha, A.M.; Mirambo, M.M.; Mshana, S.E. Aetiology of ear infection and antimicrobial susceptibility pattern among patients attending otorhinolaryngology clinic at a tertiary hospital in Dar es Salaam, Tanzania: A hospital-based cross-sectional study. BMJ Open 2023, 13, e068359. [Google Scholar] [CrossRef] [PubMed]
- Deb, T.; Ray, D. A study of the bacteriological profile of chronic suppurative otitis media in agartala. Indian J. Otolaryngol. Head Neck Surg. 2012, 64, 326–329. [Google Scholar] [CrossRef] [PubMed]
- Worku, M.; Bekele, M. Bacterial isolate and antibacterial resistance pattern of ear infection among patients attending at Hawassa university referral Hospital, Hawassa, Ethiopia. Indian J. Otol. 2014, 20, 155–159. [Google Scholar] [CrossRef]
- Orji, F.; Dike, B. Observations on the current bacteriological profile of chronic suppurative otitis media in South eastern Nigeria. Ann. Med. Health Sci. Res. 2015, 5, 124–128. [Google Scholar] [CrossRef]
- Wang, X.; Fernandez, R.; Tsivkovskaia, N.; Harrop-Jones, A.; Hou, H.J.; Dellamary, L.; Dolan, D.F.; Altschuler, R.A.; LeBel, C.; Piu, F. OTO-201: Nonclinical assessment of a sustained-release ciprofloxacin hydrogel for the treatment of otitis media. Otol. Neurotol. 2014, 35, 459–469. [Google Scholar] [CrossRef]
- Sharma, S.D.; James, A.L. The influence of ciprofloxacin–dexamethasone ear drops on perforation closure rates after endoscopic tympanoplasty. Otol. Neurotol. 2021, 42, e1644–e1647. [Google Scholar] [CrossRef]
- Redula, S.; Antonelli, P.J.; Dirain, C.O. Cytotoxicity of ciprofloxacin and steroids in mouse tympanic membrane fibroblasts. Otolaryngol. Head Neck Surg. 2018, 158, 547–552. [Google Scholar] [CrossRef]
- Prasad, S.; Mohan, N. Anti-microbial properties of human wax. Int. J. Med. Sci. Public Health 2014, 3, 96–98. [Google Scholar] [CrossRef]
- Naz, I. Assessment of antimicrobial activity of cerumen (earwax) and antibiotics against pathogenic bacteria isolated from ear pus samples. Microbiol. Res. 2020, 11, 8565. [Google Scholar] [CrossRef]
- Kiełbasa, J.; Bil, K.; Kowalczyk, A.; Zozula, N.; Latała, A.; Ślesicka, I.; Rykucka, A.; Wąs, M.; Przestrzelska, M.; Tomczewska, Z. Searching for the Holy Grail among ear drops. J. Educ. Health Sport 2024, 74, 52558. [Google Scholar] [CrossRef]
- Hara, S.; Kusunoki, T.; Nakagawa, H.; Toyoda, Y.; Nojiri, S.; Kamiya, K.; Furukawa, M.; Takata, Y.; Okada, H.; Anzai, T. Association between earwax-determinant genotypes and acquired middle ear cholesteatoma in a Japanese population. Otolaryngol. Head Neck Surg. 2022, 166, 139–145. [Google Scholar] [CrossRef] [PubMed]
- Horton, G.A.; Simpson, M.T.; Beyea, M.M.; Beyea, J.A. Cerumen management: An updated clinical review and evidence-based approach for primary care physicians. J. Prim. Care Community Health 2020, 11, 2150132720904181. [Google Scholar] [CrossRef] [PubMed]
- Nalawade, T.M.; Bhat, K.; Sogi, S.H. Bactericidal activity of propylene glycol, glycerine, polyethylene glycol 400, and polyethylene glycol 1000 against selected microorganisms. J. Int. Soc. Prev. Community Dent. 2015, 5, 114–119. [Google Scholar] [CrossRef] [PubMed]
- Srisukhumchai, C.; Kasemsiri, P.; Rattanaanekchai, T.; Srirompotong, S.; Yordpratum, U.; Sakolsinsiri, C. A comparative in vitro study on the cerumenolytic effect of docusate sodium versus 2.5% sodium bicarbonate using UV–visible absorption spectroscopy. J. Otol. 2020, 15, 99–102. [Google Scholar] [CrossRef]
- Pozdnyakova, A.; Adzhiakhmetova, S.; Sergeeva, E.; Pozdnyakov, D.; Yurtaeva, E.; Borodina, I.; Kompantsev, D. Composition and technology development of ear drops with cerumenolytic action (based on thick Viscum album L. leaves extract). Pharm. Pharmacol. 2023, 11, 482–493. [Google Scholar] [CrossRef]
- Aaron, K.; Cooper, T.E.; Warner, L.; Burton, M.J. Ear drops for the removal of ear wax. Cochrane Database Syst. Rev. 2018, 7, Cd012171. [Google Scholar] [CrossRef]
- Kussmann, M.; Ferth, A.; Obermüller, M.; Pichler, P.; Zeitlinger, M.; Wiesholzer, M.; Burgmann, H.; Poeppl, W.; Reznicek, G. Compatibility of ciprofloxacin with commercial peritoneal dialysis solutions. Sci. Rep. 2019, 9, 6512. [Google Scholar] [CrossRef]
- Prajaputra, V.; Karina, S.; Bismi, A.; Nuufus, P. The Removal of Ciprofloxacin from Water by Alue Naga and Leungah Beach Sand. In Proceedings of the IOP Conference Series: Earth and Environmental Science, Banda Aceh, Indonesia, 13–14 November 2023; p. 012058. [Google Scholar]
- Hubicka, U.; Krzek, J.; Walczak, M. Stability of ciprofloxacin and norfloxacin in the presence and absence of metal ions in acidic solution. Pharm. Dev. Technol. 2010, 15, 532–544. [Google Scholar] [CrossRef]
- Shetty, N.; Park, H.; Zemlyanov, D.; Mangal, S.; Bhujbal, S.; Zhou, Q.T. Influence of excipients on physical and aerosolization stability of spray dried high-dose powder formulations for inhalation. Int. J. Pharm. 2018, 544, 222–234. [Google Scholar] [CrossRef]
- Al-Mardini, M.A.; Mando, Z. Studying the accelerated photostability of Ciprofloxacin and Lomefloxacin in tablets and eye drops. Int. J. Pharm. Sci. Res. 2014, 5, 3646. [Google Scholar]
- DrugBank. Ciprofloxacin. Available online: https://go.drugbank.com/salts/DBSALT000293 (accessed on 6 April 2025).
- Stefanis, E.; Panayiotou, C. Prediction of Hansen solubility parameters with a new group-contribution method. Int. J. Thermophys. 2008, 29, 568–585. [Google Scholar] [CrossRef]
- Sumontri, S.; Eiamart, W.; Tadtong, S.; Samee, W. Ultra-high-performance liquid chromatography–tandem mass spectrometry analysis of Δ9-tetrahydrocannabinol and cannabidiol in commercial Suk-Saiyasna herbal remedy: Applying Hansen solubility parameters for sample extraction to ensure regulatory compliance. Pharmaceuticals 2024, 17, 1502. [Google Scholar] [CrossRef] [PubMed]
- Morizono, T.; Paparella, M.M.; Juhn, S.K. Ototoxicity of propylene glycol in experimental animals. Am. J. Otolaryngol. 1980, 1, 393–399. [Google Scholar] [CrossRef] [PubMed]
- United States Pharmacopeial Convention. General Chapters, Dissolution «711». In USP 45–NF 40; U.S. Pharmacopeia: Frederick, MD, USA, 2022; pp. 6945–6954. [Google Scholar]
- United States Pharmacopeial Convention. Validation of Analytical Procedures ICH Q2(R2) Guideline; U.S. Pharmacopeia: Frederick, MD, USA, 2023. [Google Scholar]
- AOAC. Appendix F Guidelines for Standard Method Performance Requirements. Available online: https://www.aoac.org/wp-content/uploads/2019/08/app_f.pdf (accessed on 6 April 2025).
- Şahin, M.E.; Elbir, A. Energy analysis of the absorption cooling cycle from the waste heat of the hospital sterilization unit. Environ. Prog. Sustain. Energy 2024, 43, e14305. [Google Scholar] [CrossRef]
- Long, Z.; Guo, T.; Chen, C.; Zhang, G.; Zhu, J. Preparation and application of Ag plasmon Bi3O4Cl photocatalyst for removal of emerging contaminants under visible light. Front. Microbiol. 2023, 14, 1210790. [Google Scholar] [CrossRef]
- Clark, M.P.; Pangilinan, L.; Wang, A.; Doyle, P.; Westerberg, B.D. The shelf life of antimicrobial ear drops. Laryngoscope 2010, 120, 565–569. [Google Scholar] [CrossRef]
- Chen, H.; Lee, P.; Chen, C.; Huang, S.; Huang, B.; Dai, F.; Chau, C.; Chen, C.; Lin, Y. Moisture retention of glycerin solutions with various concentrations: A comparative study. Sci. Rep. 2022, 12, 10232. [Google Scholar] [CrossRef]
- Pan, X.; Wang, Q.; Ning, D.; Dai, L.; Liu, K.; Ni, Y.; Chen, L.; Huang, L. Ultraflexible self-healing guar gum-glycerol hydrogel with injectable, antifreeze, and strain-sensitive properties. ACS Biomater. Sci. Eng. 2018, 4, 3397–3404. [Google Scholar] [CrossRef]
- Rashed, A.M.; Hetta, A.; Hashem, Z.S.; El-Katatny, M.M.H. Validation of moist and dry heat processes used for sterilization and depyrogenation during ampoules manufacturing. J. Adv. Biomed. Pharm. Sci. 2020, 3, 177–183. [Google Scholar] [CrossRef]
- Viveksarathi, K.; Kannan, K. Effect of the moist-heat sterilization on fabricated nanoscale solid lipid particles containing rasagiline mesylate. Int. J. Pharm. Investig. 2015, 5, 87. [Google Scholar]
- McCormick, P.J.; Schoene, M.J.; Pedeville, D.; Kaiser, J.J.; Conyer, J. Verification testing of biological indicators for moist heat sterilization. Biomed. Instrum. Technol. 2018, 52, 199–207. [Google Scholar] [CrossRef] [PubMed]
- Shintani, H. How to Recovery of Damaged Microorganisms by Supplying Several Sorts of Nutrients. J. Bioanal. Biomed. 2014, 6, 24–28. [Google Scholar] [CrossRef]
- Bakker-Woudenberg, I.A.; ten Kate, M.T.; Guo, L.; Working, P.; Mouton, J.W. Ciprofloxacin in polyethylene glycol-coated liposomes: Efficacy in rat models of acute or chronic Pseudomonas aeruginosa infection. Antimicrob. Agents Chemother. 2002, 46, 2575–2581. [Google Scholar] [CrossRef] [PubMed]
- Kiakojuri, K.; Tavasoli, A.; Yunesi, R.; Rajabnia, R.; Hajian, K.; Bagheri, M.; Shafiee, M.S.; Armaki, M.T.; Omran, S.M. Therapeutic effects of ciprofloxacin powder and drops in chronic bacterial middle ear infections: A clinical trial study. Jundishapur J. Microbiol. 2020, 13, e98110. [Google Scholar] [CrossRef]
- Li, T.; Mudie, S.; Cipolla, D.; Rades, T.; Boyd, B.J. Solid state characterization of ciprofloxacin liposome nanocrystals. Mol. Pharm. 2018, 16, 184–194. [Google Scholar] [CrossRef]
- Li, T.; Nowell, C.J.; Cipolla, D.; Rades, T.; Boyd, B.J. Direct comparison of standard transmission electron microscopy and cryogenic-TEM in imaging nanocrystals inside liposomes. Mol. Pharm. 2019, 16, 1775–1781. [Google Scholar] [CrossRef]

| Group | Ni | Ci | (NiCi)p | (NiCi)d | (NiCi)h | ||
|---|---|---|---|---|---|---|---|
| 1st-Order | δd | δp | δh | ||||
| COOH | 1 | −0.291 | 0.9042 | 3.7390 | −0.2910 | 0.9042 | 3.7390 |
| ACF | 1 | 0.1170 | 0.1856 | −0.7182 | 0.1170 | 0.1856 | −0.7182 |
| ACH | 3 | 0.1105 | −0.5303 | −0.4305 | 0.3315 | −1.5909 | −1.2915 |
| >C=O | 1 | −0.4343 | 0.7905 | 1.8147 | −0.4343 | 0.7905 | 1.8147 |
| -CH2N | 2 | 0.8116 | 0.9412 | 1.3400 | 1.6232 | 1.8824 | 2.6800 |
| >N [1] (in cyclic) | 3 | 0.2218 | −2.2018 | −0.0452 | 0.6654 | −6.6054 | −0.1356 |
| -CH2NH | 2 | 1.4681 | 2.8345 | 1.2505 | 2.9362 | 5.6690 | 2.5010 |
| AC | 4 | 0.8446 | 0.6187 | 0.0084 | 3.3784 | 2.4748 | 0.0336 |
| Ring of 3 carbons | 1 | 0.0200 | 1.8288 | −0.8073 | 0.0200 | 1.8288 | −0.8073 |
| ΣNiCi | 8.3464 | 5.5390 | 7.8157 | ||||
| Constant (C) | 17.3231 | 7.3548 | 7.9793 | ||||
| ΣNiCi + C | 25.6695 | 12.8938 | 15.7950 | ||||
| Name | Hansen Solubility Parameters | Ra | ||
|---|---|---|---|---|
| Solute | δd | δp | δh | |
| Ciprofloxacin | 25.6695 | 12.8938 | 15.7950 | |
| Solvent | ||||
| Water (Vehicle A) | 15.5 | 16 | 42.3 | 33.55 |
| Propylene glycol | 16.8 | 9.4 | 23.3 | 19.58 |
| Glycerin | 17.2 | 12 | 29.3 | 21.68 |
| Vehicle B | 17.03 | 12.4 | 30.6 | 22.76 |
| Vehicle C | 16.95 | 11.88 | 29.4 | 22.14 |
| Parameters | % RSD of Retention Time | % RSD of Peak Area | Resolution | Number of Theoretical Plate | Tailing Factor |
|---|---|---|---|---|---|
| Acceptance criteria | ≤2% | ≤2% | >6 | 2500 | ±1.5 |
| Results | 0.06 | 0.11 | − | 13,265 | ±1.13 |
| Linearity | Linear Equation | R2 | LOD (ng/mL) | LOQ (ng/mL) | ||
|---|---|---|---|---|---|---|
| 1 | Y = 117.55X − 3.0626 | 0.9993 | 6.14 | 18.61 | ||
| 2 | Y = 117.57X − 3.0373 | 0.9993 | ||||
| 3 | Y = 116.44X − 2.7288 | 0.9992 | ||||
| mean | Y = 117.19X − 3.0087 | 0.9995 | ||||
| Day | Concentration (µg/mL) | %Recovery | Mean recovery | SD | %RSD | |
| Actual | Found | |||||
| 1 | 0.3105 | 0.3126 | 100.68 | 99.73 | 0.8341 | 0.84 |
| 0.3025 | 0.2998 | 99.11 | ||||
| 0.3005 | 0.2987 | 99.40 | ||||
| 0.6210 | 0.6206 | 99.94 | 100.22 | 1.1958 | 1.19 | |
| 0.6050 | 0.6001 | 99.19 | ||||
| 0.6010 | 0.6102 | 101.53 | ||||
| 0.9315 | 0.9235 | 99.14 | 99.24 | 0.1166 | 0.12 | |
| 0.9075 | 0.9003 | 99.21 | ||||
| 0.9015 | 0.8958 | 99.37 | ||||
| 2 | 0.6025 | 0.6134 | 101.81 | 99.68 | 1.6571 | 1.66 |
| 0.6015 | 0.6087 | 101.20 | ||||
| 0.6005 | 0.6002 | 99.95 | ||||
| 0.6000 | 0.5947 | 99.12 | ||||
| 0.6015 | 0.5854 | 97.32 | ||||
| 0.6100 | 0.6021 | 98.70 | ||||
| 3 | 0.6075 | 0.6025 | 99.18 | 99.72 | 0.6344 | 0.64 |
| 0.6050 | 0.6003 | 99.22 | ||||
| 0.6025 | 0.5986 | 99.35 | ||||
| 0.6075 | 0.6104 | 100.48 | ||||
| 0.6100 | 0.6135 | 100.57 | ||||
| 0.6050 | 0.6022 | 99.54 | ||||
| Inter-Day | 99.71 | 1.0361 | 1.04 | |||
| Sample | %Labeled Amount | |||
|---|---|---|---|---|
| Before Sterilization | After Sterilization | |||
| Formulation B | Formulation C | Formulation B | Formulation C | |
| 1 | 104.31 | 105.06 | 102.27 | 102.71 |
| 2 | 103.37 | 105.44 | 101.73 | 99.19 |
| 3 | 102.98 | 104.41 | 100.87 | 102.23 |
| 4 | 102.91 | 102.91 | 101.93 | 100.42 |
| 5 | 102.01 | 105.84 | 100.70 | 101.19 |
| Mean ± SD | 103.12 ± 0.83 | 104.73 ± 1.15 | 101.50 ± 0.68 * | 101.15 ± 1.41 * |
| Sample | %Labeled Amount | ||||||||
|---|---|---|---|---|---|---|---|---|---|
| Day 0 | Day 3 | Day 7 | Day 14 | Day 21 | Day 30 | Day 45 | Day 60 | Day 180 | |
| 1 | 102.27 | 100.55 | 100.68 | 101.45 | 101.27 | 102.96 | 105.79 | 99.77 | 95.12 |
| 2 | 101.73 | 100.82 | 101.01 | 101.80 | 103.77 | 102.79 | 105.57 | 99.49 | 95.88 |
| 3 | 100.87 | 102.47 | 101.50 | 102.59 | 103.20 | 102.19 | 102.78 | 99.87 | 96.05 |
| 4 | 101.93 | 102.95 | 101.54 | 104.09 | 102.84 | 103.56 | 103.59 | 100.24 | 97.46 |
| 5 | 100.70 | 100.17 | 101.33 | 104.10 | 104.28 | 101.02 | 102.96 | 102.88 | 96.71 |
| Mean * | 101.50 | 101.39 | 101.21 | 102.81 | 103.07 | 102.50 | 104.14 | 100.45 | 96.24 |
| SD | 0.6816 | 1.24 | 0.36 | 1.25 | 1.15 | 0.96 | 1.44 | 1.38 | 0.92 |
| %Remaining | |||||||||
| Mean * | 100 | 99.89 | 99.72 | 101.29 | 101.55 | 100.99 | 102.60 | 98.97 | 94.82 |
| SD | 0.67 | 1.22 | 0.36 | 1.23 | 1.13 | 0.95 | 1.42 | 1.36 | 0.87 |
| Sample | %Labeled Amount | ||||||||
|---|---|---|---|---|---|---|---|---|---|
| Day 0 | Day 3 | Day 7 | Day 14 | Day 21 | Day 30 | Day 45 | Day 60 | Day 180 | |
| 1 | 102.71 | 99.31 | 104.16 | 103.10 | 104.26 | 102.75 | 104.47 | 101.55 | 95.06 |
| 2 | 99.19 | 102.16 | 103.98 | 102.34 | 101.85 | 103.25 | 105.56 | 103.59 | 96.91 |
| 3 | 102.23 | 103.04 | 103.18 | 101.75 | 103.16 | 100.91 | 105.77 | 99.47 | 97.28 |
| 4 | 100.42 | 99.14 | 100.62 | 102.62 | 102.52 | 104.19 | 104.51 | 99.73 | 95.33 |
| 5 | 101.19 | 102.82 | 102.33 | 102.14 | 101.08 | 104.66 | 104.69 | 98.92 | 95.25 |
| Mean * | 101.15 | 101.30 | 102.85 | 102.39 | 102.57 | 103.15 | 105.00 | 100.65 | 95.97 |
| SD | 1.4111 | 1.92 | 1.44 | 0.51 | 1.22 | 1.46 | 0.62 | 1.92 | 1.09 |
| %Remaining | |||||||||
| Mean * | 100.00 | 100.14 | 101.68 | 101.23 | 101.41 | 101.98 | 103.81 | 99.51 | 94.87 |
| SD | 1.39 | 1.90 | 1.43 | 0.50 | 1.21 | 1.45 | 0.61 | 1.89 | 1.03 |
Disclaimer/Publisher’s Note: The statements, opinions and data contained in all publications are solely those of the individual author(s) and contributor(s) and not of MDPI and/or the editor(s). MDPI and/or the editor(s) disclaim responsibility for any injury to people or property resulting from any ideas, methods, instructions or products referred to in the content. |
© 2025 by the authors. Licensee MDPI, Basel, Switzerland. This article is an open access article distributed under the terms and conditions of the Creative Commons Attribution (CC BY) license (https://creativecommons.org/licenses/by/4.0/).
Share and Cite
Samee, W.; Tadtong, S.; Eiamart, W.; Singwiset, P.; Yingyomsarn, S.; Nunthanavanit, P. Impact of Vehicle Composition on Solubility, Autoclave Sterilization Stability, and Antibacterial Activity of Ciprofloxacin Hydrochloride Ear Drops. Int. J. Mol. Sci. 2025, 26, 4458. https://doi.org/10.3390/ijms26094458
Samee W, Tadtong S, Eiamart W, Singwiset P, Yingyomsarn S, Nunthanavanit P. Impact of Vehicle Composition on Solubility, Autoclave Sterilization Stability, and Antibacterial Activity of Ciprofloxacin Hydrochloride Ear Drops. International Journal of Molecular Sciences. 2025; 26(9):4458. https://doi.org/10.3390/ijms26094458
Chicago/Turabian StyleSamee, Weerasak, Sarin Tadtong, Wanna Eiamart, Pattaraporn Singwiset, Sirivimon Yingyomsarn, and Patcharawee Nunthanavanit. 2025. "Impact of Vehicle Composition on Solubility, Autoclave Sterilization Stability, and Antibacterial Activity of Ciprofloxacin Hydrochloride Ear Drops" International Journal of Molecular Sciences 26, no. 9: 4458. https://doi.org/10.3390/ijms26094458
APA StyleSamee, W., Tadtong, S., Eiamart, W., Singwiset, P., Yingyomsarn, S., & Nunthanavanit, P. (2025). Impact of Vehicle Composition on Solubility, Autoclave Sterilization Stability, and Antibacterial Activity of Ciprofloxacin Hydrochloride Ear Drops. International Journal of Molecular Sciences, 26(9), 4458. https://doi.org/10.3390/ijms26094458

